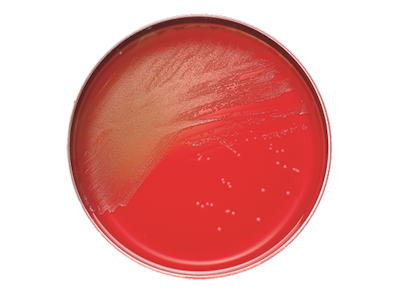
BD BBL Columbia CNA Agar with 5% Sheep Blood Plate – 20 Plates per Pack, 84-Day Shelf Life

Description
BD BBL Columbia CNA Agar with 5% Sheep Blood Plate is designed for laboratories that demand reliable and efficient culture media. When accuracy and consistency are essential for your workflow, this prepared media helps ensure dependable results every day. Ideal for clinical labs and microbiology professionals, its formulation supports rapid and luxuriant growth of gram-positive organisms, streamlining your diagnostic process.
- Selective Inhibition – Incorporates colistin and nalidixic acid to suppress gram-negative bacteria, supporting targeted growth and clearer results.
- Enriched with 5% Sheep Blood – Promotes robust growth of gram-positive organisms, giving you reliable colony development.
- Ready-to-Use Plates – Supplied in a 100-pack for high-throughput labs, saving time and reducing preparation steps.
- Consistent Performance – Manufactured to strict standards for batch-to-batch reliability, helping you work with confidence.
Prepared Culture Media for Reliable Microbiology Results
This selective agar plate is formulated to inhibit gram-negative bacteria while encouraging the growth of gram-positive organisms. Its combination of colistin and nalidixic acid, along with 5% sheep blood, makes it a trusted choice for clinical and research labs focused on accurate microbial identification. The 100-plate pack is ideal for busy labs that require consistent, ready-to-use media. Using this prepared culture medium helps streamline workflows and supports dependable diagnostic outcomes. Professionals in microbiology and clinical diagnostics benefit from its ease of use and reliable performance.
Features and Benefits
Targeted Microbial Growth
- Colistin and Nalidixic Acid Formula – Inhibits gram-negative bacteria, allowing for selective cultivation of gram-positive species.
- 5% Sheep Blood Enrichment – Supports luxuriant growth and clear hemolytic reactions for accurate organism identification.
Laboratory Efficiency
- Pre-Poured Plates – Ready for immediate use, reducing setup time and minimizing contamination risk.
- Bulk Packaging – 100 plates per pack, suitable for high-volume testing environments.
Consistent Quality
- Standardized Manufacturing – Ensures reliable results across batches for reproducible diagnostics.
- Diagnostic Accuracy – Designed to support efficient and precise laboratory workflows.
Product Specifications
General Information
- Category: Prepared culture media
- Pack Size: 100 plates/pack
- Shelf Life: 84 days
Identification and Traceability
- SKU: 221353
- GTIN (Each): 00382902213536
- GTIN (Shelfpack): 30382902213537
- GTIN (Bag): 10382902213533
- GTIN (US Standard Pallet): 60382902213538
Explore More: See all Prepared Culture Media | Shop more BD BBL Products
Reliable Performance for Demanding Labs
Choose this selective agar plate for consistent, high-quality results in your microbiology workflow. The formulation is designed to meet the needs of professionals who require dependable media for accurate organism identification. Its bulk packaging and ready-to-use format help streamline daily routines and support efficient lab operations. Rely on this product for peace of mind and steady performance in every batch.
- Selective Growth Medium – Supports targeted cultivation of gram-positive organisms, improving clarity in test results.
- Bulk 100-Pack – Reduces ordering frequency and supports high-throughput testing environments.
- Standardized Quality – Manufactured to strict specifications for reproducibility and confidence in results.
- Trusted Brand – Produced by BD BBL, a recognized leader in laboratory media solutions.
Frequently Asked Questions (FAQs)
What organisms does this agar plate support?
This medium is designed to support the growth of gram-positive bacteria while inhibiting gram-negative species.
What is the shelf life of the plates?
The plates have a shelf life of 84 days from the date of manufacture.
How many plates are included in each pack?
Each pack contains 100 pre-poured agar plates.
What is the enrichment in this medium?
This agar contains 5% sheep blood for enhanced growth and clear hemolytic reactions.
Is this product ready to use upon arrival?
Yes, the plates are pre-poured and ready for immediate use in laboratory settings.
Does this medium inhibit gram-negative bacteria?
Yes, the inclusion of colistin and nalidixic acid inhibits gram-negative organisms, allowing selective growth of gram-positive bacteria.
Who is the intended user for this product?
This product is intended for use by laboratory professionals and microbiology specialists who require reliable culture media.